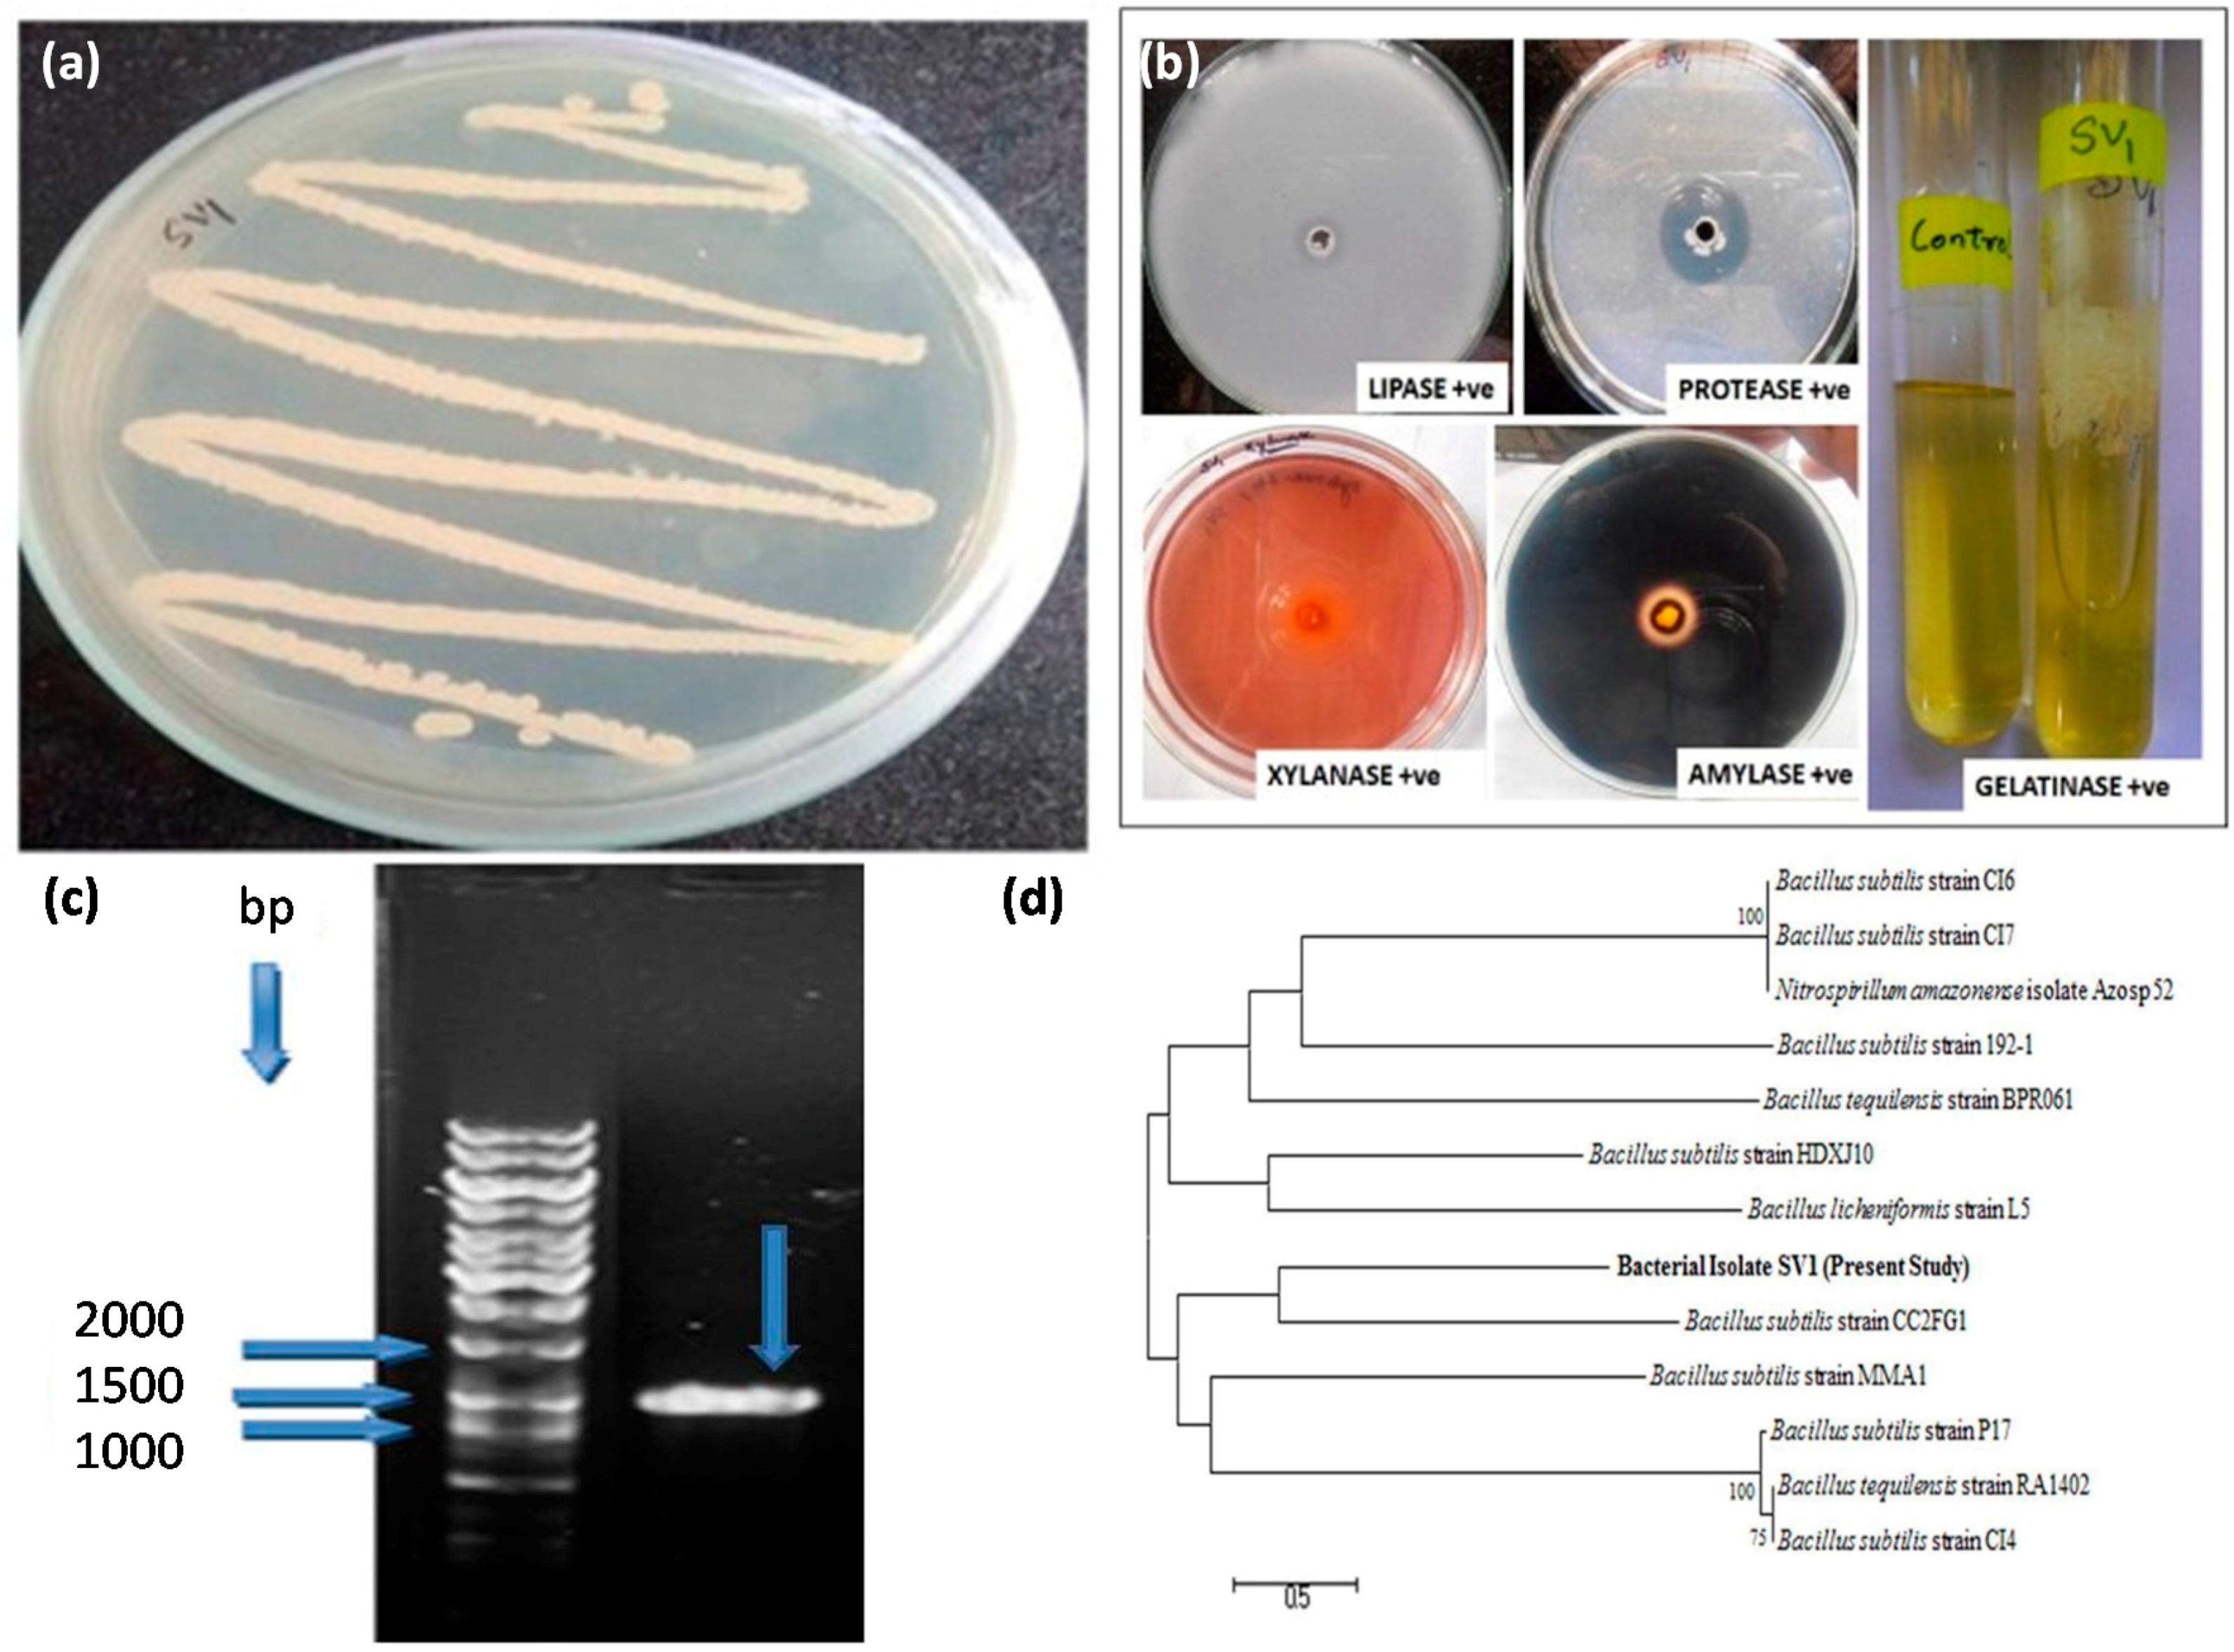

Cellulase Production from Bacillus subtilis SV1 and Its Application Potential for Saccharification of Ionic Liquid Pretreated Pine Needle Biomass under One Pot Consolidated Bioprocess
Abstract
:1. Introduction
2. Results and Discussion
2.1. Cellulolytic Bacteria
2.2. IL Stability of Cellulase
2.3. Identification of IL-stable Cellulase Producing Bacterium
2.4. DoE Based Optimization of Cultural and Environmental Variables for Cellulase Production
2.5. Some properties of B. subtilis SV1
2.6. Pretreatment and Enzymatic Saccharification under a One Pot Consolidated Bioprocess
3. Materials and Methods
3.1. Chemicals and Media
3.2. Cellulase Producing Bacteria
3.3. Submerged Fermentation for Cellulase Production
3.4. IL Stability of Bacterial Cellulases
3.5. Identification of the Selected Bacterium
3.6. Optimization of Cultural and Environmental Variables for Cellulase Production
3.7. Some Properties of IL-Stable Cellulase
3.8. Pretreatment and Enzymatic Hydrolysis of PNB Using One Pot Consolidated Bioprocess (OPCB)
3.8.1. Pine Needle Biomass (PNB)
3.8.2. One Pot Consolidated Bioprocess
4. Conclusions
Acknowledgments
Author Contributions
Conflicts of Interest
References
- Mehmood, N.; Husson, E.; Jacquard, C.; Wewetzer, S.; Büchs, J.; Sarazin, C.; Gosselin, I. Impact of two ionic liquids, 1-ethyl-3-methylimidazolium acetate and 1-ethyl-3-methylimidazolium methylphosphonate, on Saccharomyces cerevisiae: Metabolic, physiologic, and morphological investigations. Biotechnol. Biofuels 2015, 8, 8–17. [Google Scholar]
- Kumar, R.; Tabatabaei, M.; Karimi, K.; Sárvári-Horváth, I. Recent updates on lignocellulosic biomass derived ethanol: A review. Biofuel. Res. J. 2016, 3, 347–356. [Google Scholar] [CrossRef]
- Moreno, A.D.; Ibarra, D.; Mialon, A.; Ballesteros, M. A bacterial laccase for enhancing saccharification and ethanol fermentation of steam-pretreated biomass. Fermentation 2016, 2. [Google Scholar] [CrossRef]
- Singh, S.; Sambyal, M.; Vaid, S.; Singh, P.; Bajaj, B.K. Process optimization for production of ionic liquid resistant, thermostable and broad range pH-stable cellulase from Bacillus subtilis I-2. Biocatal. Biotransfor. 2015, 33, 224–233. [Google Scholar] [CrossRef]
- Vaid, S.; Bajaj, B.K. Production of ionic liquid tolerant cellulase from Bacillus subtilis G2 using agroindustrial residues with application potential for saccharification of biomass under one pot consolidated bioprocess. Waste Biomass Valor. 2016. [Google Scholar] [CrossRef]
- Badgujar, K.C.; Bhanage, B.M. Factors governing dissolution process of lignocellulosic biomass in ionic liquid: Current status, overview and challenges. Bioresour. Technol. 2015, 178, 2–18. [Google Scholar] [CrossRef] [PubMed]
- Konda, N.M.; Shi, J.; Singh, S.; Blanch, H.W.; Simmons, B.A.; Klein-Marcuschamer, D. Understanding cost drivers and economic potential of two variants of ionic liquid pretreatment for cellulosic biofuel production. Biotechnol. Biofuels 2014, 7. [Google Scholar] [CrossRef] [PubMed]
- Socha, A.M.; Parthasarathi, R.; Shi, J.; Pattathil, S.; Whyte, D.; Bergeron, M.; George, A.; Tran, K.; Stavila, V.; Venkatachalam, S.; et al. Efficient biomass pretreatment using ionic liquids derived from lignin and hemicellulose. Proc. Natl. Acad. Sci. USA 2014, 111, E3587–E3595. [Google Scholar] [CrossRef] [PubMed]
- Zhang, T.; Datta, S.; Eichler, J.; Lvanova, N.; Axen, S.D.; Kerfeld, C.A.; Chen, F.; Kyrpides, N.; Hugenholtz, P.; Cheng, J.F.; et al. Identification of a haloalkaliphilic and thermostable cellulase with improved ionic liquid tolerance. Green Chem. 2011, 13, 2083–2090. [Google Scholar] [CrossRef]
- Raddadi, N.; Cherif, A.; Daffonchio, D.; Fava, F. Halo-alkalitolerant and thermostable cellulases with improved tolerance to ionic liquids and organic solvents from Paenibacillus tarimensis isolated from the Chott El Fejej, Sahara desert, Tunisia. Bioresour. Technol. 2013, 150, 121–128. [Google Scholar] [CrossRef] [PubMed]
- Trivedi, N.; Gupta, V.; Reddy, C.R.K.; Jha, B. Detection of ionic liquid stable cellulase produced by the marine bacterium Pseudoalteromonas sp. isolated from brown alga Sargassum polycystum C. Agardh. Bioresour. Technol. 2013, 132, 313–319. [Google Scholar] [CrossRef] [PubMed]
- Ilmberger, N.; Meske, D.; Juergensen, J.; Schulte, M.; Barthen, P.; Rabausch, U.; Angelov, A.; Mientus, M.; Liebl, W.; Schmitz, R.A. Metagenomic cellulases highly tolerant towards the presence of ionic liquids-linking thermostability and halotolerance. Appl. Microbiol. Biotechnol. 2012, 95, 135–146. [Google Scholar] [CrossRef] [PubMed]
- Park, J.I.; Steen, E.J.; Burd, H.; Evans, S.S.; Redding-Johnson, A.M.; Batth, T.; Benke, P.I.; D’haeseleer, P.; Sun, N.; Sale, K.L.; et al. A thermophilic ionic liquid-tolerant cellulase cocktail for the production of cellulosic biofuels. PLoS ONE 2012, 7, e37010. [Google Scholar] [CrossRef] [PubMed]
- Salehi Jouzani, G.; Taherzadeh, M.J. Advances in consolidated bioprocessing systems for bioethanol and butanol production from biomass: A comprehensive review. Biofuel Res. J. 2015, 5, 152–195. [Google Scholar] [CrossRef]
- Xu, J.; Wang, X.; Hu, L.; Xia, J.; Wu, Z.; Xu, N.; Dai, B.; Wu, B. A novel ionic liquid-tolerant Fusarium oxysporum BN secreting ionic liquid-stable cellulase: Consolidated bioprocessing of pretreated lignocellulose containing residual ionic liquid. Bioresour. Technol. 2015, 181, 18–25. [Google Scholar] [CrossRef] [PubMed]
- Brethauer, S.; Studer, M.H. Consolidated bioprocessing of lignocellulose by a microbial consortium. Energy Environ. Sci. 2014, 7, 1446–1453. [Google Scholar] [CrossRef]
- Premalatha, N.; Gopal, N.O.; Jose, P.A.; Anandham, R.; Kwon, S.W. Optimization of cellulase production by Enhydrobacter sp. ACCA2 and its application in biomass saccharification. Front. Microbiol. 2015, 6. [Google Scholar] [CrossRef] [PubMed]
- Sharma, A.; Tewari, R.; Soni, S.K. Application of statistical approach for optimizing cmcase production by Bacillus tequilensiss 28 strain via submerged fermentation using wheat bran as carbon source. Int. J. Biol. Food Vet. Agric. Eng. 2015, 9, 76–86. [Google Scholar]
- Sharma, M.; Bajaj, B.K. Cellulase production from Bacillus subtilis MS 54 and its potential for saccharification of biphasic acid-pretreated rice straw. J. Biobased Mater. Bioenerg. 2014, 8, 449–456. [Google Scholar] [CrossRef]
- Gupta, M.; Sharma, M.; Singh, S.; Gupta, P.; Bajaj, B.K. Enahnced production of cellulase from Bacillus Licheniformis K-3 with potential saccharification of rice straw. Energy Technol. 2015, 3, 216–224. [Google Scholar] [CrossRef]
- Singh, S.; Moholkar, V.S.; Goyal, A. Optimization of carboxymethylcellulose production from Bacillus amyloliquefaciens SS35. 3 Biotech. 2013, 4, 411–424. [Google Scholar] [CrossRef]
- Vats, S.; Maurya, D.P.; Jain, A.; Mall, V.; Negi, S. Mathematical model-based optimization of physico-enzymatic hydrolysis of Pinus roxburghii needles for the production of reducing sugars. Indian J. Exp. Biol. 2013, 51, 944–953. [Google Scholar] [PubMed]
- Singh, S.; Anu, S.V.; Singh, P.; Bajaj, B.K. Physicochemical pretreatment of pine needle biomass by design of experiments approach for efficient enzymatic saccharification. J. Mater. Environ. Sci. 2016, 7, 2034–2041. [Google Scholar]
- Liang, Y.L.; Zhang, Z.; Wu, M.; Wu, Y.; Feng, X.J. Isolation, screening, and identification of cellulolytic bacteria from natural reserves in the subtropical region of China and optimization of cellulase production by Paenibacillus terrae ME27–1. Bio. Med. Res. Int. 2014. [Google Scholar] [CrossRef]
- Trivedi, N.; Gupta, V.; Kumar, M.; Kumari, P.; Reddy, C.R.K.; Jha, B. Solvent tolerant marine bacterium Bacillus aquimaris secreting organic solvent stable alkaline cellulase. Chemosphere 2011, 83, 706–712. [Google Scholar] [CrossRef] [PubMed]
- Sethi, S.; Datta, A.; Gupta, B.L.; Gupta, S. Optimization of cellulase production from bacteria isolated from soil. ISRN Biotechnol. 2013. [Google Scholar] [CrossRef] [PubMed]
- Yin, L.J.; Lin, H.H.; Xiao, Z.R. Purification and characterization of a cellulase from Bacillus subtilis YJ1. J. Mar. Sci. Technol. 2010, 18, 466–471. [Google Scholar]
- Gaur, R.; Tiwari, S. Isolation, production, purification and characterization of an organic-solvent-thermostable-alkalophilic cellulase from Bacillus vallismortis RG-07. BMC Biotechnol. 2015, 15, 19–31. [Google Scholar] [CrossRef] [PubMed]
- Zhao, K.; Guo, L.Z.; Lu, W.D. Extracellular production of novel halotolerant, thermostable, and alkali-stable carboxymethyl cellulase by marine bacterium Marinimicrobium sp. LS-A18. Appl. Biochem. Biotechnol. 2012, 168, 550–567. [Google Scholar] [CrossRef] [PubMed]
- Trivedi, N.; Gupta, V.; Kumar, M.; Kumari, P.; Reddy, C.R.K.; Jha, B. An alkali-halotolerant cellulase from Bacillus flexus isolated from green seaweed Ulva lactuca. Carbohydr. Polym. 2011, 82, 891–897. [Google Scholar] [CrossRef]
- Shi, J.; Gladden, J.M.; Sathitsuksanoh, N.; Kambam, P.; Sandoval, L.; Mitra, D.; Zhang, S.; George, A.; Singer, S.W.; Simmonsa, B.A.; et al. One-pot ionic liquid pretreatment and saccharification of switchgrass. Green Chem. 2013, 15, 2579–2589. [Google Scholar] [CrossRef]
- Qing, Q.; Hu, R.; He, Y.; Zhang, Y.; Wang, L. Investigation of a novel acid-catalyzed ionic liquid pretreatment method to improve biomass enzymatic hydrolysis conversion. Appl. Microbiol. Biotechnol. 2014, 98, 5275–5286. [Google Scholar] [CrossRef] [PubMed]
- Nasirpour, N.; Mousavi, S.M.; Shojaosadati, S.A. A novel surfactant-assisted ionic liquid pretreatment of sugarcane bagasse for enhanced enzymatic hydrolysis. Bioresour. Technol. 2014, 169, 33–37. [Google Scholar] [CrossRef] [PubMed]
- An, Y.X.; Zong, M.H.; Wu, H.; Li, N. Pretreatment of lignocellulosic biomass with renewable cholinium ionic liquids: biomass fractionation, enzymatic digestion and ionic liquid reuse. Bioresour. Technol. 2015, 192, 165–171. [Google Scholar] [CrossRef] [PubMed]
- Bahrani, S.; Raeissi, S.; Sarshar, M. Experimental investigation of ionic liquid pretreatment of sugarcane bagasse with 1,3-dimethylimadazolium dimethyl phosphate. Bioresour. Technol. 2015, 185, 411–415. [Google Scholar] [CrossRef] [PubMed]
- Hou, X.D.; Li, N.; Zong, M.H. Significantly enhancing enzymatic hydrolysis of rice straw after pretreatment using renewable ionic liquid–water mixtures. Bioresour. Technol. 2013, 136, 469–474. [Google Scholar] [CrossRef] [PubMed]
- Miller, G.L. Use of dinitrosalicylic acid reagent for determination of reducing sugar. Anal. Chem. 1959, 31, 426–428. [Google Scholar] [CrossRef]

| Microorganism | Ionic Liquid (IL) | IL Concentration (%) | Stability (Residual/Relative Activity, %) | Reference |
|---|---|---|---|---|
| Bacillus subtilis I-2 | 1-ethyl-3-methylimidazolium methanesulfonate | 10 | 93–98 | 4 |
| Bacillus subtilis G2 | 1-ethyl-3-methylimidazolium methanesulfonate (EMIMS) | 20–50 | 95–100 | 5 |
| 1-butyl-3-methylimidazolium chloride | ||||
| 1-ethyl-3-methylimidazolium bromide | ||||
| 1-ethyl-3-methylimidazolium acetate | ||||
| 1-butyl-3-methylimidazolium trifluoro methanesulfonate | ||||
| Halorhabdus utahensis | 1-Ethyl-3-methylimidazolium acetate ([Emim]Ac) | 20 | 100 (Remained unchanged) | 9 |
| 1-ethyl-3-methylimidazolium chloride ([Emim]Cl | Slightly increased | |||
| 1-butyl-3-methylimidazolium chloride ([Bmim]Cl) | Slightly increased | |||
| 1-allyl-3-methylimidazolium chloride | 100 (remained unchanged) | |||
| Pseudoalteromonas sp. | 1-ethyl-3-methylimidazolium Methanesulfonate | 20 | 59 | 11 |
| 1-ethyl-3-methylimidazolium bromide | 67 | |||
| 1-ethyl-3-methylimidazolium acetate | 93.47 | |||
| 1-butyl-1-methylpyrrolidinium trifluromethanesulfonate | 80.2 | |||
| 1-butyl-3-methylimidazolium trifluoromethanesulfonate | 74.69 | |||
| 1-butyl-3-methylimidazolium trifluoromethanesulfonate | 73.2 | |||
| Fusarium oxysporum BN | 1-ethyl-3-methyl-imidazolium dimethylphosphate | 10 | 93 | 15 |
| 1-ethyl-3-methyl-imidazolium methylphosphonate | More than 84 | |||
| 1-ethyl-3-methylimidazolium Phosphinate | More than 74 | |||
| Bacillus subtilis SV1 | 1-ethyl-3-methylimidazolium methanesulfonate | 10–50 | 72.9–98.12 | Present study |
| Runs | Experimental Variables * | Response (Enzyme Activity, IU/mL) | ||||
|---|---|---|---|---|---|---|
| Run number | A | B | C | D | Experimental | Predicted |
| 1 | 1.5 | 1.5 | 5 | 72 | 0.66 | 0.64 |
| 2 | 1.5 | 3.0 | 9 | 72 | 1.97 | 2.18 |
| 3 | 2.25 | 2.25 | 7 | 48 | 1.89 | 1.77 |
| 4 | 1.5 | 1.5 | 9 | 72 | 2.31 | 2.02 |
| 5 | 2.25 | 2.25 | 7 | 48 | 1.82 | 1.77 |
| 6 | 1.5 | 3.0 | 9 | 24 | 1.80 | 1.66 |
| 7 | 2.25 | 2.25 | 7 | 96 | 1.85 | 1.91 |
| 8 | 1.5 | 1.5 | 5 | 24 | 1.26 | 1.11 |
| 9 | 2.25 | 2.25 | 7 | 48 | 1.19 | 1.77 |
| 10 | 3.0 | 1.5 | 9 | 24 | 2.05 | 1.98 |
| 11 | 2.25 | 3.75 | 7 | 48 | 1.99 | 2.02 |
| 12 | 3.75 | 2.25 | 7 | 48 | 2.29 | 2.91 |
| 13 | 3.0 | 3.0 | 9 | 72 | 3.04 | 2.79 |
| 14 | 1.5 | 3.0 | 5 | 72 | 1.70 | 1.36 |
| 15 | 2.25 | 0.75 | 7 | 48 | 1.08 | 1.33 |
| 16 | 1.5 | 1.5 | 9 | 24 | 1.98 | 1.81 |
| 17 | 2.25 | 2.25 | 11 | 48 | 2.25 | 2.28 |
| 18 | 1.5 | 3.0 | 5 | 24 | 1.63 | 1.51 |
| 19 | 3.0 | 1.5 | 5 | 72 | 1.90 | 1.64 |
| 20 | 3.0 | 3.0 | 5 | 72 | 2.21 | 2.49 |
| 21 | 3.0 | 3.0 | 5 | 24 | 2.43 | 2.32 |
| 22 | 3.0 | 3.0 | 9 | 24 | 1.81 | 1.95 |
| 23 | 3.0 | 1.5 | 9 | 72 | 2.25 | 2.50 |
| 24 | 2.25 | 2.25 | 7 | 0 | 1.32 | 1.54 |
| 25 | 2.25 | 2.25 | 7 | 48 | 1.90 | 1.77 |
| 26 | 2.25 | 2.25 | 3 | 48 | 1.02 | 1.28 |
| 27 | 2.25 | 2.25 | 7 | 48 | 1.97 | 1.77 |
| 28 | 3.0 | 1.5 | 5 | 24 | 1.89 | 1.80 |
| 29 | 0.75 | 2.25 | 7 | 48 | 1.26 | 1.62 |
| 30 | 2.25 | 2.25 | 7 | 48 | 1.87 | 1.77 |
| Source | Sum of Squares | DF | Mean Squares | F Value | Prob > F | Significance |
|---|---|---|---|---|---|---|
| Model | 6.64 | 14 | 0.47 | 5.18 | 0.0015 | Significant |
| A | 2.49 | 1 | 2.49 | 27.23 | 0.0001 | Significant |
| B | 0.71 | 1 | 0.71 | 7.78 | 0.0138 | Significant |
| C | 1.50 | 1 | 1.50 | 16.35 | 0.0011 | Significant |
| D | 0.21 | 1 | 0.21 | 2.26 | 0.1533 | - |
| A2 | 0.41 | 1 | 0.41 | 4.51 | 0.0507 | - |
| B2 | 0.017 | 1 | 0.017 | 0.19 | 0.6694 | - |
| C2 | 2.574 × 10−5 | 1 | 2.574 × 10−5 | 2.813 × 10−4 | 0.9868 | - |
| D2 | 3.727 × 10−3 | 1 | 3.727 × 10−3 | 0.041 | 0.8428 | - |
| AB | 0.016 | 1 | 0.016 | 0.17 | 0.6859 | - |
| AC | 0.27 | 1 | 0.27 | 2.97 | 0.1051 | - |
| AD | 0.099 | 1 | 0.099 | 1.08 | 0.3146 | - |
| BC | 0.30 | 1 | 0.30 | 3.33 | 0.0879 | - |
| BD | 0.11 | 1 | 0.11 | 1.15 | 0.3007 | - |
| CD | 0.45 | 1 | 0.45 | 4.93 | 0.0422 | Significant |
| Residual | 1.37 | 15 | 0.092 | - | ||
| Lack of fit | 0.95 | 10 | 0.095 | 1.14 | 0.4714 | Not significant |
| Pure Error | 0.42 | 5 | 0.084 | - | ||
| Cor Total | 8.01 | 29 | - |
| Study Type: Response Surface | Experiments: 30 | |||
|---|---|---|---|---|
| Initial Design: Central Composite | Design Model: Quadratic | |||
| Response | Name | Units | ||
| Y | Enzyme activity | IU/mL | Experimental values | |
| Factors | Name | Units | Lower | Higher |
| A | Wheat Bran | %, w/v | 1.5 | 3 |
| B | Spirulina powder | %, w/v | 1.5 | 3 |
| C | Medium pH | - | 5 | 9 |
| D | Incubation time | H | 24 | 72 |
| Runs | Experimental variables * | |||
|---|---|---|---|---|
| Run number | A | B | C | D |
| 1 | 1.5 | 1.5 | 5 | 72 |
| 2 | 1.5 | 3.0 | 9 | 72 |
| 3 | 2.25 | 2.25 | 7 | 48 |
| 4 | 1.5 | 1.5 | 9 | 72 |
| 5 | 2.25 | 2.25 | 7 | 48 |
| 6 | 1.5 | 3.0 | 9 | 24 |
| 7 | 2.25 | 2.25 | 7 | 96 |
| 8 | 1.5 | 1.5 | 5 | 24 |
| 9 | 2.25 | 2.25 | 7 | 48 |
| 10 | 3.0 | 1.5 | 9 | 24 |
| 11 | 2.25 | 3.75 | 7 | 48 |
| 12 | 3.75 | 2.25 | 7 | 48 |
| 13 | 3.0 | 3.0 | 9 | 72 |
| 14 | 1.5 | 3.0 | 5 | 72 |
| 15 | 2.25 | 0.75 | 7 | 48 |
| 16 | 1.5 | 1.5 | 9 | 24 |
| 17 | 2.25 | 2.25 | 11 | 48 |
| 18 | 1.5 | 3.0 | 5 | 24 |
| 19 | 3.0 | 1.5 | 5 | 72 |
| 20 | 3.0 | 3.0 | 5 | 72 |
| 21 | 3.0 | 3.0 | 5 | 24 |
| 22 | 3.0 | 3.0 | 9 | 24 |
| 23 | 3.0 | 1.5 | 9 | 72 |
| 24 | 2.25 | 2.25 | 7 | 0 |
| 25 | 2.25 | 2.25 | 7 | 48 |
| 26 | 2.25 | 2.25 | 3 | 48 |
| 27 | 2.25 | 2.25 | 7 | 48 |
| 28 | 3.0 | 1.5 | 5 | 24 |
| 29 | 0.75 | 2.25 | 7 | 48 |
| 30 | 2.25 | 2.25 | 7 | 48 |
© 2016 by the authors; licensee MDPI, Basel, Switzerland. This article is an open access article distributed under the terms and conditions of the Creative Commons Attribution (CC-BY) license (http://creativecommons.org/licenses/by/4.0/).
Share and Cite
Nargotra, P.; Vaid, S.; Bajaj, B.K. Cellulase Production from Bacillus subtilis SV1 and Its Application Potential for Saccharification of Ionic Liquid Pretreated Pine Needle Biomass under One Pot Consolidated Bioprocess. Fermentation 2016, 2, 19. https://doi.org/10.3390/fermentation2040019
Nargotra P, Vaid S, Bajaj BK. Cellulase Production from Bacillus subtilis SV1 and Its Application Potential for Saccharification of Ionic Liquid Pretreated Pine Needle Biomass under One Pot Consolidated Bioprocess. Fermentation. 2016; 2(4):19. https://doi.org/10.3390/fermentation2040019
Chicago/Turabian StyleNargotra, Parushi, Surbhi Vaid, and Bijender Kumar Bajaj. 2016. "Cellulase Production from Bacillus subtilis SV1 and Its Application Potential for Saccharification of Ionic Liquid Pretreated Pine Needle Biomass under One Pot Consolidated Bioprocess" Fermentation 2, no. 4: 19. https://doi.org/10.3390/fermentation2040019
APA StyleNargotra, P., Vaid, S., & Bajaj, B. K. (2016). Cellulase Production from Bacillus subtilis SV1 and Its Application Potential for Saccharification of Ionic Liquid Pretreated Pine Needle Biomass under One Pot Consolidated Bioprocess. Fermentation, 2(4), 19. https://doi.org/10.3390/fermentation2040019
